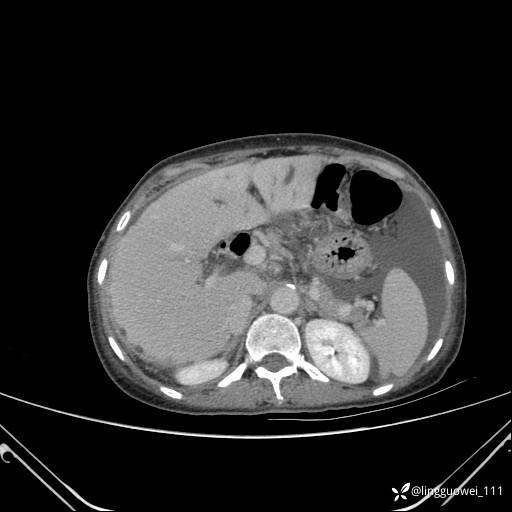
img

女,65岁,门诊行胃肠镜检查后,说腹胀入院检查,CT能发现病因吗?已公布结果


患者性别:女
患者年龄:65岁
主诉:门诊行胃肠镜检查后,诉腹胀,入院检查,肝有病变吗?腹膜及腹腔的表现有特征性吗?
平扫:






增强动脉期:





门脉期:










延迟期:

最后编辑于 2024-03-26 · 浏览 2032
患者性别:女
患者年龄:65岁
主诉:门诊行胃肠镜检查后,诉腹胀,入院检查,肝有病变吗?腹膜及腹腔的表现有特征性吗?
平扫:
增强动脉期:
门脉期:
延迟期:
最后编辑于 2024-03-26 · 浏览 2032